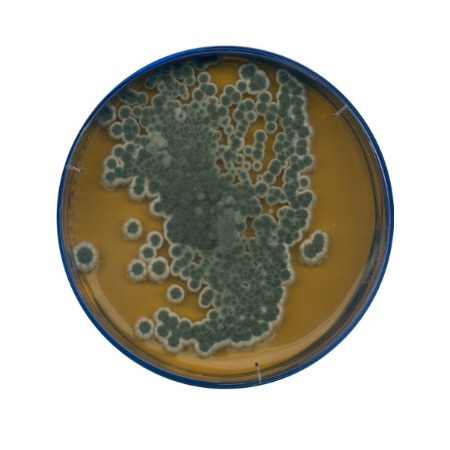

Merck offers chemicals, reagents and labware for applications in laboratories and industry: biosciences, biopharma, food, cosmetics, LCDs, pharmaceuticals, printing, plastics and coating. Company provides scientists and engineers with best-in-class lab materials, technologies and services. With the 2015 combination of Merck Millipore and Sigma-Aldrich, now the manufacturer has a broad portfolio of 300,000 products.
Contact us for getting a price offer for desired Merck products.